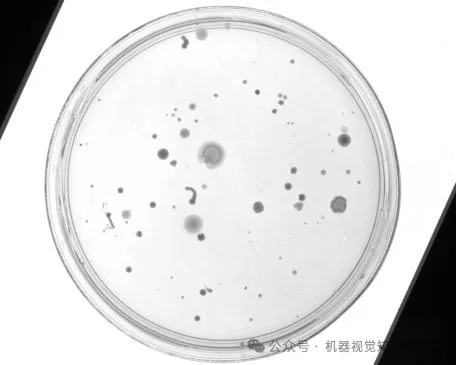
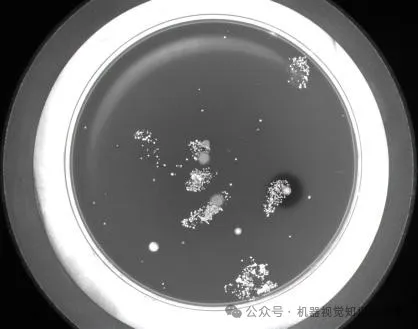

introduction
The light source in a machine vision system is a key component for achieving high-quality image capture. Proper light source not only improves the quality of the image, but also affects the detection efficiency and accuracy of the vision system. Choosing the right light source can significantly improve the overall performance of the system, simplify the image processing process, and improve the accuracy of detection.

Shooting under different light sources
The influence of light source
The choice of light source directly affects the image quality and effect of the machine vision system. As shown in the figure, different light sources can produce different imaging effects, which will further affect the selection and optimization of the detection algorithm. For example, using light sources of different colors and intensities can highlight certain features or hide irrelevant details, thereby simplifying algorithm processing requirements.


Red light source filters out red text
case analysis
In practical applications, it is crucial to choose the right light source according to the specific needs of the task. For example, when detecting objects with complex surface features, choosing the right light source can significantly improve contrast and recognition rate. In a case involving metal parts detection, by using a light source with a specific wavelength, the interference caused by surface reflection can be reduced and the detection accuracy can be improved.



in conclusion
